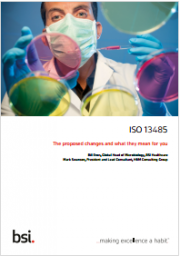
The new ISO 13485:2016 standard is published

Linee Guida gestione del sistema d'informazione rapida RAPEX

Linee Guida gestione del sistema d'informazione rapida RAPEX
L'EFTA adotta le Linee Guida RAPEX
Linee guida dell'Autorità di vigilanza dell'EFTA per la gestione del sistema d'informazione rapida «RAPEX» e della procedura di…
Leggi tutto Linee Guida gestione del sistema d'informazione rapida RAPEXEN 12547:2009 Centrifughe - Requisiti comuni di sicurezza - Testo pdf

EN 12547:2009 Centrifughe - Requisiti comuni di sicurezza
Requisiti di cui ai punti:
5. REQUISITI E MISURE DI SICUREZZA
6. VERIFICA DEI REQUISITI E DELLE MISURE DI SICUREZZA
7. INFORMAZIONI PER L'USO
8. MARCATURA, SEGNALI E AVVERTENZE…
RAPEX Report 13 del 01/04/2016 N. 19 A12/0392/16 Islanda

RAPEX: Rapid Alert System for Non-Food Consumer Products
Report 13 del 01/04/2016
N.19 A12/0392/16 Islanda
Approfondimento tecnico: Portachiavi con giocattolo collegato
Il prodotto “Neyðarkallinn” è stato volontariamente ritirato dal mercato perché non conforme…
Leggi tutto RAPEX Report 13 del 01/04/2016 N. 19 A12/0392/16 IslandaRegolamento (UE) 2016/424: Impianti a fune

Regolamento impianti a fune / Consolidato 31.03.2016
Regolamento (UE) 2016/424 del Parlamento Europeo e del Consiglio del 9 marzo 2016 relativo agli impianti a fune e che abroga la direttiva…
Leggi tutto Regolamento (UE) 2016/424: Impianti a funeBimbi sicuri

Bimbi sicuri
La sicurezza nel mondo del bambino
Sono 2 le pubblicazioni della Camera di Commercio di Milano dedicate alla sicurezza nel mondo dei bambini, l'Edizione Estiva e l'Edizione Invernale.
Edizione…
Leggi tutto Bimbi sicuriRAPEX Report 12 del 25/03/2016 N.28 A11/0030/16 Francia

RAPEX: Rapid Alert System for Non-Food Consumer Products
Report 12 del 25/03/2016
N.28 A11/0030/16 Francia
Approfondimento tecnico: Peluche
Il prodotto, di marca ZEEMAN, è stato ritirato volontariamente dal mercato perché non…
Leggi tutto RAPEX Report 12 del 25/03/2016 N.28 A11/0030/16 FranciaRelazione fonometrica Direttiva macchine

Relazione di rilievo fonometrico Direttiva macchine / Rev. 4.0 2023
ID 342 | Rev. 4.0 del 24.01.2023
Il Documento è un modello per il rilievo fotometrico del…
Guidelines ecodesign requirements for Electric Motor

Guidelines ecodesign requirements for Electric Motor
Commission Regulation 640/2009 of 22 July 2009 implementing Directive 2005/32/EC whith regard to ecodesign requirements for Electric Motors and No 4/2014 of 6 January 2014…
Leggi tutto Guidelines ecodesign requirements for Electric MotorFocus Istruzioni d'uso e Marcature Gru caricatrici EN 12999

Focus Istruzioni d'Uso e marcature Gru caricatrici EN 12999:2020
ID 1542 | 11.11.2021 / Documento di approfondimento in allegato
Documento di approfondimento sulle istruzioni per l’uso e le marcature…
Leggi tutto Focus Istruzioni d'uso e Marcature Gru caricatrici EN 12999Divieto di immissione sul mercato macchina spellafili: Decisione (UE) 382/2016

Divieto di immissione sul mercato di macchina spellafili: Decisione di Esecuzione (UE) 382/2016
DECISIONE DI ESECUZIONE (UE) 2016/382 DELLA COMMISSIONE del 15 marzo 2016 relativa a una misura adottata dalla Germania in conformità…
Leggi tutto Divieto di immissione sul mercato macchina spellafili: Decisione (UE) 382/2016Technical documentation of Directive 2009/48/EC on the Safety Toys - Rev. 1.5 2016

Guidance document on the application of Directive 2009/48/EC on the Safety Toys
Technical documentation
In order to ensure compliance with the essential safety requirements, it was necessary to lay down appropriate…
D.Lgs 15 febbraio 2016, n. 26: Attuazione nuova Direttiva PED 2014/68/UE

Decreto Legislativo 15 febbraio 2016, n. 26 / Attuazione Direttiva PED
ID 2369 | 12.03.2016 / Nuova Direttiva PED 2014/68/UE Attuata
Attuazione della direttiva 2014/68/UE del Parlamento europeo e del…
Leggi tutto D.Lgs 15 febbraio 2016, n. 26: Attuazione nuova Direttiva PED 2014/68/UEEsame approfondito di piattaforme elevabili EN 1570-1

Esame approfondito di piattaforme elevabili EN 1570-1
Check list conformità alla norma EN 1570-1
Il Documento specifica i requisiti per l'esame approfondito di piattaforme di sollevamento per il sollevamento e/o abbassando…
Dispositivi di ritenuta del veicolo: Sicurezza e Prestazioni

Dispositivi di ritenuta del veicolo: Sicurezza e sulle prestazioni
Questo documento definisce la sicurezza, le prestazioni, e fornisce raccomandazioni per quanto riguarda l'applicazione di dispositivi di ritenuta del veicolo.
Per individuare il…
Guidelines for application to Electrical Power Drive Systems

Guidelines for application to Electrical Power Drive Systems
CE Marking and Technical Standardisation Edition 4
Electrical Power Drive Systems (PDSs), including Complete Drive Modules (CDMs) and Basic Drive Modules (BDMs), are inherently…
Rettifica Norme armonizzate Direttiva macchine Gennaio 2016
Rettifica alla comunicazione della Commissione nel quadro dell'esecuzione della direttiva 2006/42/CE del Parlamento europeo e del Consiglio del 17 maggio 2006 relativa alle macchine e che modifica la direttiva 95/16/CE (rifusione)
(Gazzetta ufficiale dell’Unione europea C 14 del 15 gennaio 2016)
(2016/C 84/08)
Norme armonizzate Direttiva macchine Gennaio 2016
Leggi tutto Rettifica Norme armonizzate Direttiva macchine Gennaio 2016Direttiva Emissioni da Macchine Mobili non Stradali (NRMMD)

Direttiva 97/68/CE / Emissioni da Macchine Mobili non Stradali (NRMMD)
ID 2355 | Update news 09.01.2024
[box-info]Abrogazione Direttiva 97/68/CE
Regolamento (UE) 2016/1628 del Parlamento europeo e del Consiglio del 14 settembre 2016…
Leggi tutto Direttiva Emissioni da Macchine Mobili non Stradali (NRMMD)Equipaggiamenti Elettrici: i Requisiti previsti da EN 60204-1

Equipaggiamenti Elettrici: i Requisiti previsti da EN 60204-1
EN 60204-1:2006 Requisiti
Sicurezza del macchinario
Equipaggiamento elettrico delle macchine Parte 1: regole generali
Varianti: A1:2010 - EC:2010
La EN 60204-1 si applica all'equipaggiamento elettrico utilizzato in una grande varietà…
Guida al passaggio dalla Direttiva ATEX 94/9/CE alla nuova Direttiva ATEX 2014/34/UE

Guida al passaggio dalla Direttiva ATEX 94/9/CE alla nuova Direttiva ATEX 2014/34/UE
La nuova direttiva ATEX 2014/34/UE è il risultato dell'allineamento della direttiva ATEX precedente 94/9/CE per il "nuovo quadro normativo"…
Divieto immissione sul mercato generatore di corrente: Decisione (UE) 2016/530

Decisione di Esecuzione (UE) 2016/530
Decisione di Esecuzione (UE) 2016/530 della Commissione dal 1° aprile 2016 relativa a una misura adottata dalla Germania in conformità alla direttiva 2006/42/CE del Parlamento europeo…
Leggi tutto Divieto immissione sul mercato generatore di corrente: Decisione (UE) 2016/530Regolamento (UE) 2016/426: Apparecchi a gas

Regolamento (UE) 2016/426 "Apparecchi a gas"
ID 2444 | Update news 03.04.2024
Regolamento (UE) 2016/426 del Parlamento Europeo e del Consiglio del 9 marzo 2016 sugli apparecchi che bruciano…
Leggi tutto Regolamento (UE) 2016/426: Apparecchi a gasCD/DVD Supporti radiografici: esclusi Dispositivi medici

CD/DVD Supporti radiografici: esclusi Dispositivi medici
I Supporti per la registrazione di immagini radiografiche (CD-R/DVD-R) sono esclusi dalla Direttiva Dispositivi medici 93/42/CEE e non devono essere marcati CE.
Risultano disponibili sul…
Leggi tutto CD/DVD Supporti radiografici: esclusi Dispositivi mediciDirettiva click

Direttiva click:
le comunicazioni delle norme armonizzate aggiornate quotidianamente
Il materiale pubblicato in questo spazio è estratto direttamente dal sito dell'Unione Europea Eurlex e può essere scaricato e utilizzato liberamente senza restrizione…
RAPEX Report 11 del 18/03/2016 N.52 A12/1992/13 Finlandia

RAPEX: Rapid Alert System for Non-Food Consumer Products
Report 11 del 18/03/2016
N.52 A12/1992/13 Finlandia
Approfondimento tecnico: Sega circolare
Il prodotto, marca MAX PRO, Mod. LG405 / 1094, 2011/2261, è stato sottoposto alla…
Leggi tutto RAPEX Report 11 del 18/03/2016 N.52 A12/1992/13 FinlandiaMarcatura CE Dispositivi medici utilizzati come DPI

Marcatura CE Dispositivi medici utilizzati come DPI
Documento interpretativo sulla marcatura CE di dispositivi medici (DM) destinati ad essere utilizzati in conformità delle disposizioni in materia di dispositivi di protezione individuale (DPI).…
Leggi tutto Marcatura CE Dispositivi medici utilizzati come DPIDT Oleoidraulica EN ISO 4413:2010 (UNI 2012)

Documento Tecnico Rev. 2.0.2014
Oleoidraulica EN ISO 4413:2010 (UNI 2012)
Info generali e Modulo raccolta dati per la conformità
1. Focus Tecnico Estratto Norma tecnica EN ISO 4413:2010 [pdf]
2. Modulo…
Decreto dirigenziale del 10 luglio 2015 MISE

Decreto dirigenziale del 10 luglio 2015
Divieto di immissione sul mercato rasaerba fabbricato da GGP Italy SpA
Con il Decreto dirigenziale del 10 luglio 2015, è data esecuzione sul mercato domestico della Decisione…
Regolamento Delegato (UE) 2016/364

Reazione al fuoco: Classificazione prestazione Prodotti da Costruzione Regolamento (UE) 305/2011 CPR
ID 2393 | Update news 07.06.2022
Regolamento Delegato (UE) 2016/364 della Commissione dal 1° luglio 2015
relativo alla…
Guidance document on the application of Directive 2009/48/EC on the Safety Toys - Rev. 1.9 2016

Guidance document on the application of Directive 2009/48/EC on the Safety Toys
The technological developments in the toys market have raised new issues with respect to the safety of toys, and…
RAPEX Report 10 del 11/03/2016 N. 35 A12/0313/16 Irlanda

RAPEX: Rapid Alert System for Non-Food Consumer Products
Report 10 del 11/03/2016
N.35 A12/0313/16 Irlanda
Approfondimento tecnico: Borotalco
Il prodotto, marca “Cotton Free”, è stato volontariamente ritirato dal mercato perché non conforme…
Leggi tutto RAPEX Report 10 del 11/03/2016 N. 35 A12/0313/16 IrlandaThe new ISO 13485:2016 standard is published
The new ISO 13485:2016 standard is published
Introducing the new ISO 13485 Medical devices. Quality management systems. Requirements for regulatory purposes.
The latest edition of ISO 13485, the internationally recognized quality…
Leggi tutto The new ISO 13485:2016 standard is publishedVIII Conferenza Nazionale sui Dispositivi Medici

VIII Conferenza Nazionale sui Dispositivi Medici
Raccolta degli Atti della Conferenza
La Conferenza Nazionale sui Dispositivi Medici, (Roma, 17 - 18 dicembre) è un appuntamento istituzionale giunto alla sua 8^ edizione.
La…
Leggi tutto VIII Conferenza Nazionale sui Dispositivi MediciEfficacia delle protezioni rigide delle seghe circolari squadratrici

Efficacia delle protezioni rigide delle seghe circolari squadratrici
ID 2366 | 28.05.2025 / In allegato
RAPEX Report 9 del 04 Marzo 2016 N.1/A11/0020/16 Germania

RAPEX: Rapid Alert System for Non-Food Consumer Products
Report 09 del 04/03/2016
N.18 A11/0020/16 Germania
Approfondimento tecnico: Lubrificante per le valvole degli strumenti musicali
Il prodotto, lubrificante per le valvole degli strumenti musicali,…
Leggi tutto RAPEX Report 9 del 04 Marzo 2016 N.1/A11/0020/16 GermaniaTransition Provisions & Exemptions for Non Road Mobile Machinery Engines

Transition Provisions & Exemptions for Non Road Mobile Machinery Engines (Includes Flexibility & Replacement Engines)
CECE Guidelines
Exhaust Emission Directive 97/68/EC as amended by 2011/88/EU (Directive NRMM)
This document concerns the…
Macchine da piccola perforazione

Macchine da piccola perforazione
Altri articoli...
- Schema di decreto legislativo attuazione direttiva 2014/35/UE BassaTensione
- Schema di decreto legislativo attuazione direttiva 2014/30/UE EMC
- Schema di decreto legislativo attuazione direttiva 2014/34/UE ATEX
- RAPEX Report 08 del 26/02/2016 N.18 A12/0218/16 Bulgaria
- Child Product Safety Guide: Potentially dangerous products






































